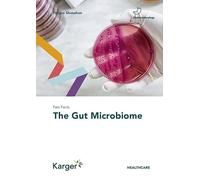
Fast Facts: The Gut Microbiome

£27.34
Amazon-marketplace.co.uk
Delivery from £2.99

Sharma - Fast Facts for the Primary FRCA and EDAIC Basic Science for - P555z
£205.22
ebay.co.uk
Free Delivery

£25.13
Amazon-marketplace.co.uk
Delivery from £2.80

£22.17
Amazon-marketplace.co.uk
Delivery from £4.95

£35.00
Amazon-marketplace.co.uk
Delivery from £2.50
£15.85
amazon.co.uk
Free Delivery

£37.51
Amazon-marketplace.co.uk
Delivery from £7.74

£27.34
Amazon-marketplace.co.uk
Delivery from £2.99

£17.77
Amazon-marketplace.co.uk
Delivery from £7.74

£14.97
Amazon-marketplace.co.uk
Delivery from £7.74

£27.34
Amazon-marketplace.co.uk
Delivery from £2.99

£14.07
Amazon-marketplace.co.uk
Delivery from £2.80

£27.34
Amazon-marketplace.co.uk
Delivery from £2.99

£34.82
Amazon-marketplace.co.uk
Delivery from £2.80

£11.33
Amazon-marketplace.co.uk
Delivery from £2.80

Fast Facts: Liver Disorders
£35.27
Amazon-marketplace.co.uk
Delivery from £2.80

£45.89
Amazon-marketplace.co.uk
Delivery from £2.80

£20.55
amazon.co.uk
Free Delivery

Reversing Peripheral Neuropathy Fast: Detailed Guide on Peripheral Neuropathy; Types, Causes & Signs; Diagnosis & Efficient Treatments; Including Natural Treatments, Amazing Facts & Lots More
£7.26
amazon.co.uk
Delivery from £2.99

£31.71
Amazon-marketplace.co.uk
Delivery from £7.74

Famous Scientists For Kids: A Young Scientist’s Intro to the Lives and Contributions of 75 Famous Scientists as Well as Fast Facts on 15 Astonishing Scientific Discoveris in the History.
£15.99
amazon.co.uk
Free Delivery

Fast Facts: Type 2 Diabetes: Identify Early, Intervene Effectively, Make Every Contact Count
£27.34
Amazon-marketplace.co.uk
Delivery from £2.99

Fast Facts: Dermatoses in Skin of Color
£15.81
amazon.co.uk
Free Delivery

Fast Facts: Excessive Daytime Sleepiness Associated with Obstructive Sleep Apnea
£27.34
Amazon-marketplace.co.uk
Delivery from £2.99

Fast Facts: Inflammatory Bowel Disease: Translating the Science into Compassionate IBD Care
£27.34
Amazon-marketplace.co.uk
Delivery from £2.99

Fast Facts: Osteoporosis
£12.20
Amazon-marketplace.co.uk
Delivery from £2.80

Fast Facts: Prostate Cancer
£27.34
Amazon-marketplace.co.uk
Delivery from £2.99

Fast Facts: Myelofibrosis: Reviewed by Professor Ruben A. Mesa
£27.34
Amazon-marketplace.co.uk
Delivery from £2.99

Fast Facts: Myeloproliferative Neoplasms
£27.34
Amazon-marketplace.co.uk
Delivery from £2.99

Fast Facts: Benign Gynaecological Disease
£14.25
Amazon-marketplace.co.uk
Free Delivery

Fast Facts: Ovarian Cancer
£27.34
Amazon-marketplace.co.uk
Delivery from £2.99

Fast Facts: Epilepsy in Children and Young People
£29.51
Amazon-marketplace.co.uk
Delivery from £7.74

Fast Facts for the Family Medicine Board Review
£59.50
Amazon-marketplace.co.uk
Free Delivery

£37.90
Amazon-marketplace.co.uk
Delivery from £7.74

£11.83
Amazon-marketplace.co.uk
Free Delivery

Fast Facts for Patients and their Supporters: Inflammatory Bowel Disease: Ulcerative Colitis and Crohn's Disease
£20.80
Amazon-marketplace.co.uk
Delivery from £2.99

£13.49
Amazon-marketplace.co.uk
Delivery from £2.80

Asthma (Fast Facts for Patients and Their Supporters)
£22.41
Amazon-marketplace.co.uk
Delivery from £2.99
🤖 Ask ChatGPT
🛍️ What are the most important purchase criteria?
💰 Tell me the best deals!
📋 Create a short summary!
Informations about "fast facts medical"
Having searched the market for the cheapest prices of sale, 115 bids were found for comparison.
Furthermore, a large number of products in 33 relevant categories with a price range from £7.26 to £205.22 were found.
About "fast facts medical"
- Overall, our search showed 3 different online stores for your product "fast facts medical", including Amazon-marketplace.co.uk, amazon.co.uk and ebay.co.uk.
- After having chosen your brands you may also choose the delivery company. 1 delivery producers are available Health Press being the most popular.
- The most bids (19) were found in the price range from £27.00 to £27.99.
- Furthermore, other users were also interested in the following product: .
- Personalise your product by choosing one of the 0 shades.
Don't forget your voucher code:
Report Illegal Concerns
You are about to report a violation based on the EU Digital Services Act (DSA).